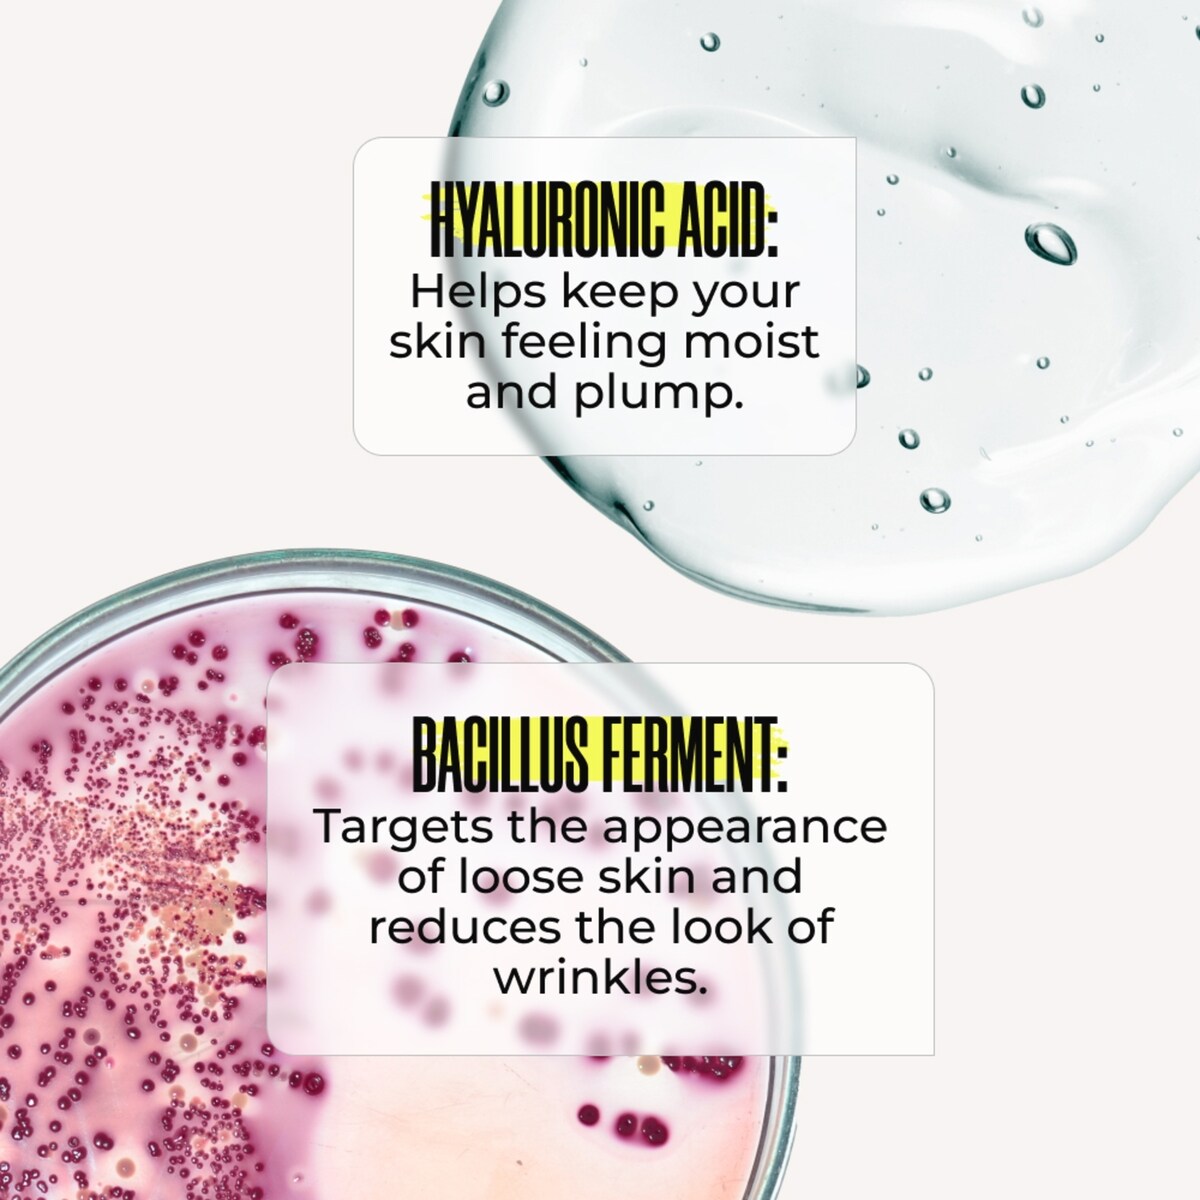
RE-SOLVE Age Defying Body Serum

GIVE THE PERFECT GIFT
Erin Mills Town Centre Gift Cards are the perfect choice for your gift giving needs.Purchase gift cards at kiosks near the food court or centre court, at Guest Services, or click below to purchase online.PURCHASE HEREHome
RE-SOLVE Age Defying Body Serum
Beauty Boutique
Loading Inventory...
RE-SOLVE Age Defying Body Serum
By MAËLYS
Current price: $87.99
Original price: $109.99

By MAËLYS
RE-SOLVE Age Defying Body Serum
Current price: $87.99
Original price: $109.99
Loading Inventory...
Size: 100.0 mL
*Product information may vary - to confirm product availability, pricing, shipping and return information please contact Beauty Boutique
MAËLYS RE-SOLVE Age-Defying Body Serum is clinically proven to improve the appearance of wrinkles, target the appearance of loose skin and strengthen the skin barrier. The lightweight texture absorbs quickly and can easily be layered under your favorite MAËLYS reshaping product for maximum results.
- Helps to improve the appearance of fine lines and wrinkles<br><br> Targets the appearance of loose skin<br><br> Strengthens the skin barrier<br><br> Powered by Hyaluronic Fusion™ technology, this high-performance anti-aging body serum delivers active ingredients, Hyaluronic Acid and Bacillus Ferment, deeply into your skin to reduce the look of fine lines, wrinkles and crepey skin.<br><br> Key Ingredients:<ul> <li>Bacillus Ferment: Targets the appearance of loose skin and reduces the look of wrinkles</li> <li>Hyaluronic Acid: Helps keep your skin feeling moist and plump</li> <li>Free of: Parabens, SLS and Phthalates</li></ul><br> MAËLYS formulas go through rigorous clinical trials conducted on panels of real women. The trial found that RE-SOLVE is:<ul> <li>Clinically proven to improve the look of wrinkles on the skin</li> <li>Clinically proven to improve the look of crepey skin</li> <li>Clinically proven to visibly hydrate the skin</li> <li>*Based on a 56-day clinical trial with 22 participants</li>
- MAËLYS most advanced formula gives visible results in 30 days. Follow these steps:<br><br> Apply a thin layer to visible fine lines and wrinkles on your body. Massage in circular motions until fully absorbed. Use twice a day for best results. Pair with our bestselling body reshapers to complete your regimen. Apply the serum first and wait for it to fully absorb before applying other products.<br><br> Boost Your Regimen! Pair with bestselling body reshapers like B-POISED Neck & Décolleté Firming Cream or B-FLEX Lift and Firm Arm Cream to complete your regimen.<br><br>
- Water (Aqua, Eau), Propanediol, Glycerin, Hydrolyzed Hyaluronic Acid, Aloe Barbadensis Leaf Juice, Silica, Citric Acid, Bacillus Ferment, Benzoic Acid, Sorbic Acid, Sodium Phytate, Sodium PCA, Sodium Benzoate, Erythritol, Carrageenan, Lecithin, Potassium Sorbate, Hydroxyacetophenone, Xanthan Gum, Sclerotium Gum, Polyglyceryl-6 Ricinoleate, Polyglyceryl-4 Caprate, Polyglyceryl-3 Cocoate, Polyglyceryl-6 Caprylate, Phenoxyethanol, Fragrance (Parfum), Limonene.
MAËLYS RE-SOLVE Age-Defying Body Serum is clinically proven to improve the appearance of wrinkles, target the appearance of loose skin and strengthen the skin barrier. The lightweight texture absorbs quickly and can easily be layered under your favorite MAËLYS reshaping product for maximum results.
- Helps to improve the appearance of fine lines and wrinkles<br><br> Targets the appearance of loose skin<br><br> Strengthens the skin barrier<br><br> Powered by Hyaluronic Fusion™ technology, this high-performance anti-aging body serum delivers active ingredients, Hyaluronic Acid and Bacillus Ferment, deeply into your skin to reduce the look of fine lines, wrinkles and crepey skin.<br><br> Key Ingredients:<ul> <li>Bacillus Ferment: Targets the appearance of loose skin and reduces the look of wrinkles</li> <li>Hyaluronic Acid: Helps keep your skin feeling moist and plump</li> <li>Free of: Parabens, SLS and Phthalates</li></ul><br> MAËLYS formulas go through rigorous clinical trials conducted on panels of real women. The trial found that RE-SOLVE is:<ul> <li>Clinically proven to improve the look of wrinkles on the skin</li> <li>Clinically proven to improve the look of crepey skin</li> <li>Clinically proven to visibly hydrate the skin</li> <li>*Based on a 56-day clinical trial with 22 participants</li>
- MAËLYS most advanced formula gives visible results in 30 days. Follow these steps:<br><br> Apply a thin layer to visible fine lines and wrinkles on your body. Massage in circular motions until fully absorbed. Use twice a day for best results. Pair with our bestselling body reshapers to complete your regimen. Apply the serum first and wait for it to fully absorb before applying other products.<br><br> Boost Your Regimen! Pair with bestselling body reshapers like B-POISED Neck & Décolleté Firming Cream or B-FLEX Lift and Firm Arm Cream to complete your regimen.<br><br>
- Water (Aqua, Eau), Propanediol, Glycerin, Hydrolyzed Hyaluronic Acid, Aloe Barbadensis Leaf Juice, Silica, Citric Acid, Bacillus Ferment, Benzoic Acid, Sorbic Acid, Sodium Phytate, Sodium PCA, Sodium Benzoate, Erythritol, Carrageenan, Lecithin, Potassium Sorbate, Hydroxyacetophenone, Xanthan Gum, Sclerotium Gum, Polyglyceryl-6 Ricinoleate, Polyglyceryl-4 Caprate, Polyglyceryl-3 Cocoate, Polyglyceryl-6 Caprylate, Phenoxyethanol, Fragrance (Parfum), Limonene.